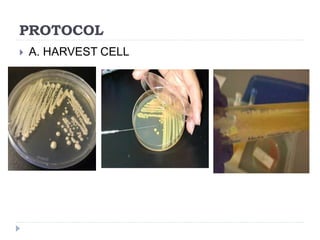
PROTOCOL
 A. HARVEST CELL

RNA isolation is the process of purifying RNA from biological samples. Three common methods are described:
1) Organic extraction methods use phenol and chloroform to separate RNA into an aqueous phase, providing rapid stabilization of RNA but being labor intensive.
2) Filter-based methods use spin baskets and membranes to bind and isolate RNA through centrifugation, providing convenience but risking clogging and retaining gDNA.
3) Magnetic particle methods use paramagnetic beads coated with molecules to bind RNA, which can then be rapidly collected in a magnetic field and resuspended for easier processing than organic extractions. All methods aim to isolate RNA while inhibiting RNases.